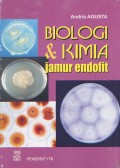
image

Kewirausahaan: inovasi dan legalitas bisnis
- Edisi
- -
- ISBN/ISSN
- 978-602-6697-65-3
- Deskripsi Fisik
- xii, 356 hlm.; 23,5 cm
- Judul Seri
- -
- No. Panggil
- 338.04/Dar/k
- Edisi
- -
- ISBN/ISSN
- 978-602-6697-65-3
- Deskripsi Fisik
- xii, 356 hlm.; 23,5 cm
- Judul Seri
- -
- No. Panggil
- 338.04/Dar/k
Hasil Pencarian
Ditemukan 1 dari pencarian Anda melalui kata kunci: Pengarang : Handayani, Erna
Permintaan membutuhkan 0.00055 detik untuk selesai

Karya Umum
Karya Umum  Filsafat
Filsafat  Agama
Agama  Ilmu-ilmu Sosial
Ilmu-ilmu Sosial  Bahasa
Bahasa  Ilmu-ilmu Murni
Ilmu-ilmu Murni  Ilmu-ilmu Terapan
Ilmu-ilmu Terapan  Kesenian, Hiburan, dan Olahraga
Kesenian, Hiburan, dan Olahraga  Kesusastraan
Kesusastraan  Geografi dan Sejarah
Geografi dan Sejarah